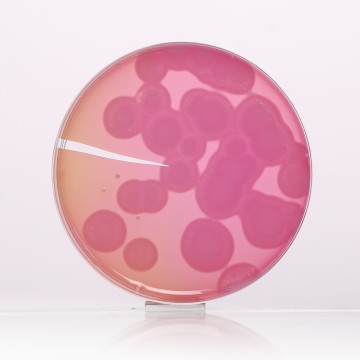
MYP Agar Base, Granulated  (Phenol Red Egg Yolk Polymyxin  Agar Base, Granulated)

Your enquiry has been submitted
MYP Agar Base
Composition**
| Ingredients | Gms / Litre |
|---|---|
| HM Peptone B # | 1.000 |
| Peptone | 10.000 |
| Mannitol | 10.000 |
| Sodium chloride | 10.000 |
| Phenol red | 0.025 |
| Agar | 15.000 |
| Final pH (at 25°C) | 7.2±0.2 |
**Formula adjusted, standardized to suit performance parameters
# Equivalent to Beef extract
Directions
Suspend 23.01 grams in 450 ml distilled water. Heat to boiling to dissolve the medium completely. Sterilize by autoclaving at 15 lbs pressure (121°C) for 15 minutes. Cool to 45-50°C. Aseptically add rehydrated contents of 1 vial of sterile Polymyxin B Sulphate (FD003) solution to a final concentration of 100 units per ml and 25 ml sterile Egg Yolk Emulsion (FD045F). Mix well and pour into sterile Petri plates.
Principle And Interpretation
MYP Agar Base is used for isolation and identification of Bacillus cereus in accordance with FDA BAM(1). B. cereus is ubiquitously present in soil, on vegetables, and in many raw and processed foods, meat, cereals, pasteurized fresh milk and powdered milk (2-4) and other processed foods. Under favourable conditions, the organism multiplies and causes gastrointestinal illness (4). It is implicated in two different forms of food poisoning; an emetic illness and a diarrhoeal illness. The emetic illness is mediated by a highly stable toxin that survives high temperature, exposure to trypsin, pepsin and pH extremes. The diarrhoeal illness is mediated by a heat and acid labile enterotoxin. Lecithinase activity is the key reaction in the differential identification of B.cereus, the commonly encountered and important species in clinical laboratories, from the majority of the other Bacillus species. If unknown isolate produces lecithinase, Bacillus cereus can be presumptively identified by also observing colony morphology, hemolytic reactivity and motility tests.
MYP Agar Base (M636F) is recommended by FDA BAM to isolate and enumerate B.cereus from foods (5, 4). This medium differentiates B.cereus from other bacteria on the basis of lecithinase activity, mannitol fermentation and resistance to polymyxin (FD003) (5, 6).
Peptone and HM Peptone B provide nitrogen and carbon source, long chain amino acids, vitamins and other essential nutrients. Mannitol acts as the carbon source that upon fermentation yields yellow colour to the colonies. Egg yolk emulsion aids in the differentiation of lecithinase producing colonies, which are surrounded by a zone of white precipitate. Polymixin B Sulphate acts as the inhibitor to restrict the growth of gram negative bacteria. These properties also help in the differentiation of B.cereus from other bacillus species (1).
Quality Control
Appearance: Light yellow to light pink homogeneous free flowing powder
Gelling: Firm, comparable with 1.5% Agar gel
Colour and Clarity of prepared medium:
- Basal medium :Red coloured clear to slightly opalescent gel.
- After Addition of Egg Yolk Emulsion (FD045) : Light orange coloured opaque gel forms in Petri plates
Reaction: Reaction of 4.6% w/v aqueous solution at 25°C. pH : 7.2±0.2
Cultural Response
Cultural characteristics observed with added Egg Yolk Emulsion (FD045)and Polymyxin B Sulphate(FD003) after an incubation at 32°C for 18-40 hours.
| Organism | Inoculum (CFU) | Growth | Recovery | Colour of colony | Lecithinase activity |
|---|---|---|---|---|---|
| Bacillus cereus ATCC 10876 | 50-100 | luxuriant | >=50% | red | positive, opaque zone around the colony |
| Bacillus subtilis ATCC 6633 | 50-100 | luxuriant | >=50% | yellow | negative |
| Escherichia coli ATCC 25922 | 50-100 | none-poor | <=10% | ||
| Proteus mirabilis ATCC 25933 | 50-100 | luxuriant | >=50% | red | negative |
| Pseudomonas aeruginosa ATCC 27853 | 50-100 | none-poor | <=10% | ||
| Staphylococcus aureus ATCC 25923 | 50-100 | luxuriant | >=50% | yellow | positive, opaque zone around the colony |
Storage and Shelf Life
Store below 30°C in tightly closed container and the prepared medium at 2 - 8°C. Use before expiry date on the label.
| Product Name | MYP Agar Base |
|---|---|
| SKU | M636F |
| Product Type | Regular |
| Physical Form | Powder |
| Origin | Animal |
| Packaging type | HDPE |
| References | 1.FDA, U.S. 199 2.Bergdoll, M. S. 1981. Clin. Microbiol. Newsletter, 3: 85-87. 3.Centers for Disease Control: Bacillus cereus- Maine, MMWR, 35: 408-410, 1986. 4.Donovan, K. O. 195 5.Downes, F.P. and Ito, K. 2001. Methods For The Microbiological Examination of Foods. APHA, Food 4 ed. Washington, D.C. 6.Nygren, B. 196 2.Acta Path. Microbiol. Scand, 56(Suppl. 1). |